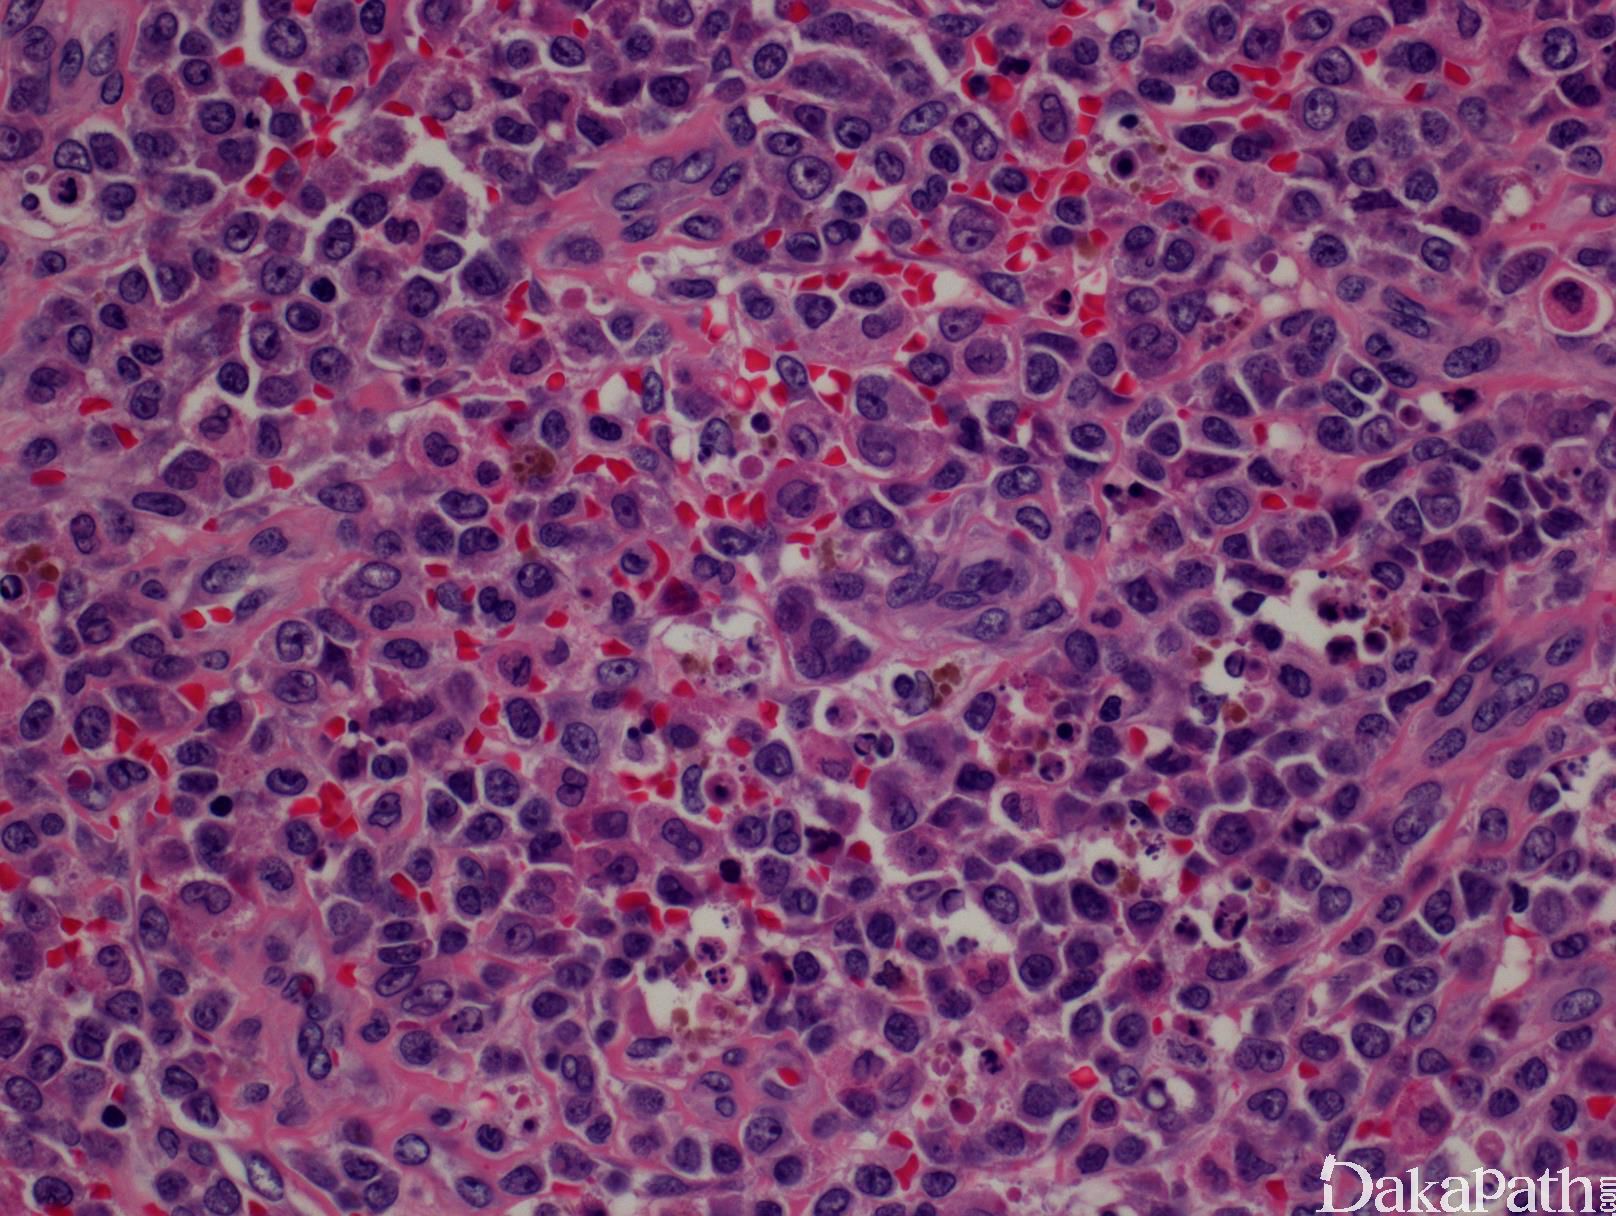

髓系肉瘤
Myeloid Sarcoma
同义词(或曾用名): 绿色瘤;粒细胞肉瘤
概述:
髓系肉瘤是指髓系原始细胞在髓外增殖,伴或不伴有相对成熟成分,形成瘤性肿块并破坏原有的组织结构。可为原发或与髓系肿瘤并发;也可是髓系肿瘤发生的前兆或髓系肿瘤治疗后的复发,或 MDS、MPN 的白血病转化。无论当时外周血和骨髓是否正常,髓系肉瘤等同于急性髓系白血病。
诊断要点:
- 任何年龄都可发病(1-89 岁),但多见于老年。可发生于髓外的任何部位,最常见的是皮肤、淋巴结、消化道、
软组织等。少数发生于有干细胞移植病史或化疗病史患者。
- 形态学:原始细胞弥漫增生,正常组织结构完全或部分破坏;可呈粘附性生长,类似转癌。细胞形态多为原始粒细
胞,伴或不伴幼粒或成熟粒细胞;也可以是粒-单核原始细胞或原始单核细胞。 如存在三系成分或较多红系或巨核细
胞,则要考虑髓系增生性肿瘤的急性白血病转化。
- 免疫表型: 髓系肉瘤的原始细胞表达粒系或粒-单核系抗原,如 CD13. CD33. CD64. MPO,CD34. CD117. CD34. CD68. CD163. lysozyme。CD43 阳性,有助于与非淋巴造血肿瘤相鉴别。罕见巨核系来源的髓系肉瘤,表达 CD61 或
CD41;罕见红系来源泽表达 glycophorin、hemoglobin-A 或 CD71。少数病例表达 CD56(不论细胞来源);约 16%病例
组化染色 NPM1 阳性,说明此基因有突变;一般不表达 B 或 T 淋巴细胞特异抗原,但有极少报道合并淋系抗原表达。如
抗原表达满足混合表型急性白血病,则不能诊断为髓系肉瘤。
- 遗传学:近 55%病例有遗传学改变,如-7. +8. +4 、+11. -16. 、 -5q 、-16q 、-20q、 inv(16)、
t(9;11)/KMT2A/MLLT3 、NPM1 mutation、t(8;21) 等。inv(16) 与肿瘤局部伴浆细胞样树突细胞分化有关,t(9;11)和
NPM1 mutation 则伴粒-单分化,t(8;21)多见于儿童。

鉴别诊断:
- 淋巴瘤 :髓系肉瘤细胞形态可以类似淋巴瘤,如弥漫大 B 细胞淋巴瘤、套细胞淋巴瘤亚型、淋巴母细胞淋巴瘤等。系统淋系及相关抗原检测和髓系抗原检测,有助鉴别。 需注意的是髓系肉瘤可表达 CD2. CD56. CD7,伴 t(8;21)的髓系肉瘤可表达 CD19 和 PAX5。
- 非淋巴造血系统肿瘤 :形态学可以有相似之处,但表达相应肿瘤抗原,不表达 CD43 和髓系抗原。
- 母细胞性浆细胞样树突细胞肿瘤 :单一形态的原始样细胞弥漫增生,无分化成熟中的粒-单核成分。肿瘤细胞表达 CD4. CD56. CD123. TCL1,不表达 CD34. MPO、溶菌酶、B 及 T 细胞特异抗原。
- 髓外组织白血病细胞/髓系肿瘤细胞浸润 :不形成瘤性肿块,不破坏正常组织结构。
